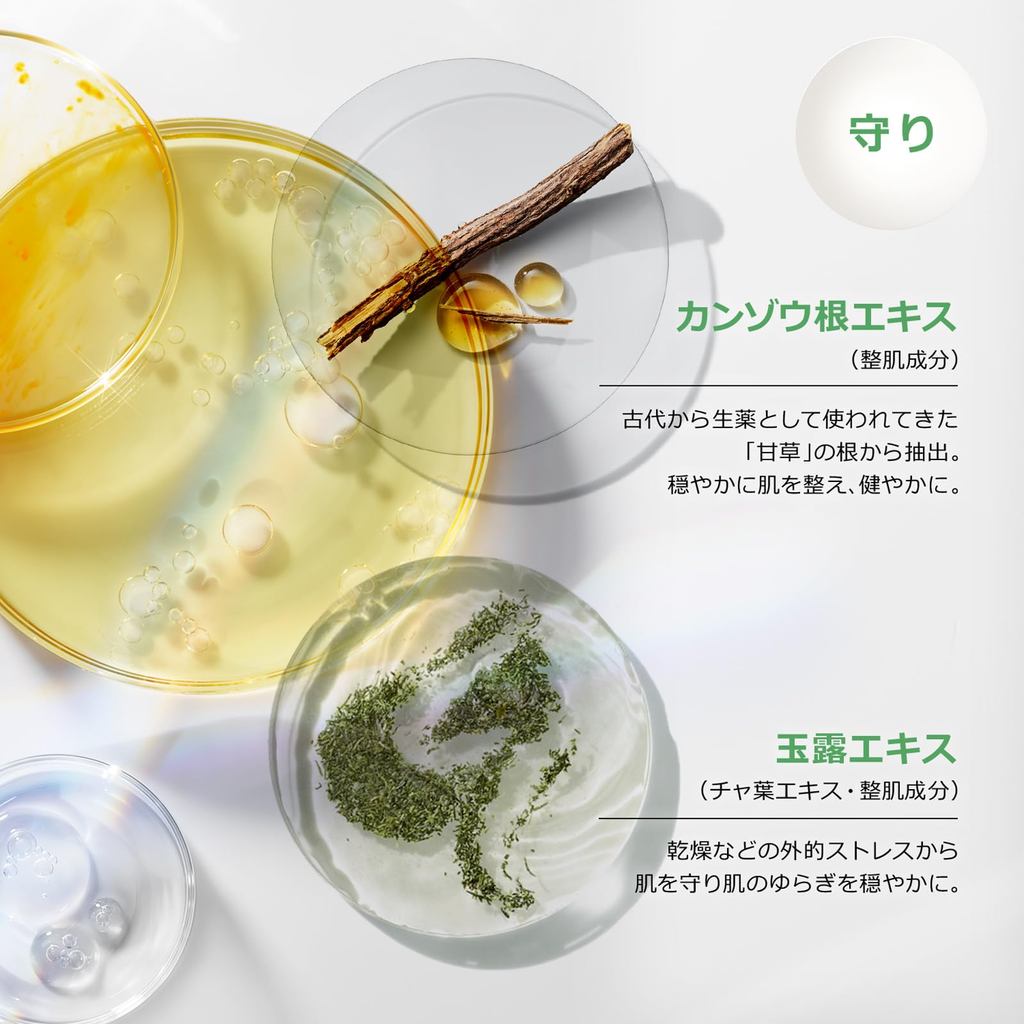

1/12
2 Variations Available
After Voucher
Clinique Even Better Illuminating Bright Serum | Gift Premium Skincare【Direct from Japan】
Guaranteed to get by 27 Apr - 6 May
Free shipping
Get a ₱50 voucher if your order arrives late.
Free & Easy Returns • Product Liability Protection